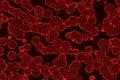
modern design red many organic micro organisms computer graphic background illustration Royalty Free Stock Photo

design modern lot biological unicellulars computer graphic background texture illustration
|
||||||||||||||
|
|
|
||||||||||||
|
||||||||||||||
Stockphotos.ro (c) 2025. All stock photos are provided by Dreamstime and are copyrighted by their respective owners.